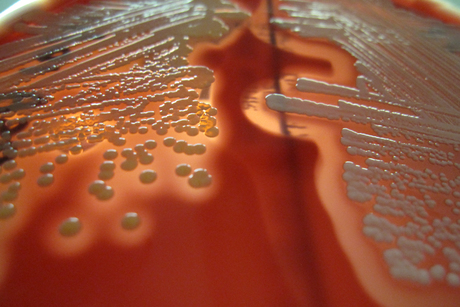

Antibiotics start-up company Auspherix launches
Today saw the launch of early-stage anti-infectives company Auspherix, which will develop novel antibiotics to treat resistant bacterial disease. The company has received $1 million in financing from the Medical Research Commercialisation Fund (MRCF).
Auspherix will in-license intellectual property from the ithree institute at the University of Technology Sydney (UTS), emerging from research led by ithree Director Professor Ian Charles and Senior Research Fellow Dr Dagmar Alber. Professor Charles and Dr Alber previously worked together at UK anti-infectives company Arrow Therapeutics, co-founded by Professor Charles.
“We are seeing more and more cases of drug-resistant bacteria around the world,” Professor Charles said. “With the rise of resistant superbugs, we desperately need to find new ways to combat infectious diseases.”
The ithree team has been using a library screening approach to identify drugs with novel mechanisms of action as antibiotics. Auspherix, through the MRCF investment, will develop a lead optimisation program to improve the antibiotic activity of the drugs identified through the screening program. The funding will also be used to establish initial safety and efficacy data in in vivo models.
Auspherix will adopt a virtual business model, with research being undertaken by the ithree founding scientists as well as through partners in the UK. Subject to meeting milestones, the company will seek further investment or industry partnerships to move the novel antibiotics into preclinical and clinical development, potentially for broad spectrum use.
Stephen Thompson, director of Auspherix and partner at Brandon Capital, the venture capital firm that manages the MRCF, said, “Auspherix is an early but exciting opportunity. The approach that the ithree scientists have taken could help to bring a new class of anti-infectives to market.”
Australia’s Chief Scientist Professor Ian Chubb stated in July that antibiotic resistance had the potential to become one of the world’s biggest public health challenges. Professor Charles said he is “hopeful, based on our early findings, that research from the ithree institute will make a contribution” to combating this challenge.
Could this psychedelic compound reduce post-concussion symptoms?
Few effective therapies exist for concussion. Now, an Australian clinical trial is exploring...
Turning point — optimal antibiotics for golden staph bloodstream infections
Involving more than 150 hospitals across more than 14 countries, a global clinical trial supports...
Alloy implants that naturally dissolve after healing
Australian researchers have been developing biodegradable magnesium-based alloys that more...



